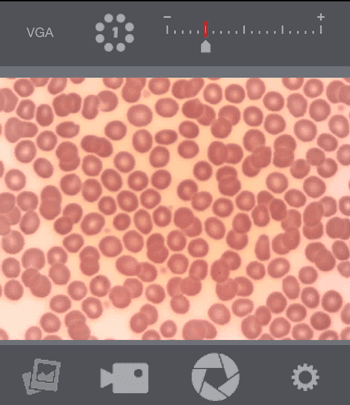

DINOCONNECT
POUŽIJTE SVŮJ DINO-LITE MIKROSKOP BEZDRÁTOVĚ, SE ZAŘÍZENÍM IPAD, IPHONE NEBO JINÝM MOBILNÍM ZAŘÍZENÍM

BEZDRÁTOVÝ MIKROSKOP

Ideální pro práci v terénu, při výuce a prezentacích. WiFi Streamer umožňuje živé vysílání z kompatibilního Dino-Lite do kompatibilního mobilního zařízení. Vysílání až na 15 m (50 st.). Současné vysílání do různých zařízení.
ŠIROKÁ KOMPATIBILITA

s iOS, Android a dalšími mobilními zařízeními
WiFi Streamer použijte s většinou modelů Dino-Lite USB a se zařízeními iOS, Android a dalšími.
WiFi Streamer použijte s většinou modelů Dino-Lite USB a se zařízeními iOS, Android a dalšími.

ŽIVÝ PŘENOS
Bezdrátově přeneste živé video z Dino-Lite do svého mobilního zařízení

ZACHYŤTE SNÍMKY A VIDEO
K zachycení snímků a videa použijte aplikace iPhone/iPad nebo Android

VYSÍLÁNÍ AŽ NA 15M
Vysílání až na 15m (50 stop) a do různých zařízení
SNÍMKY

STÁHNOUT MOBILNÍ APLIKACI
Oznámení:
Pro uživatele se zařízením Android OS, kteří nemají přístup ke Google Play, si prosím nainstalujte DinoConnect z následujícího odkazu.
www.dino-lite.com/support/DinoConnect_android_2.23.apk
Pro uživatele se zařízením Android OS, kteří nemají přístup ke Google Play, si prosím nainstalujte DinoConnect z následujícího odkazu.
www.dino-lite.com/support/DinoConnect_android_2.23.apk
Overview | |
---|---|
Operating System Supported | iOS 8.0 or later Android 4.4 or later |
Interface | WF-10’s WF-20’s Wi-Fi signal |
Support Models | Dino-Lite Basic AM2111 (R10 or later) Dino-Lite Premier AM3111 (R4 or later) AM3113 (R4 or later) AD4013/4113 (R4 or later) AM4013/4113 (R4 or later) AD7013 (R4 or later) AM7013 (R4 or later) AF3111HT/3113 AF4113-EUT Dino-Lite Edge AM4115/4515/4815 AF4115/4515/4915 AM7115/7515/7915 Dino-Eye Premier AM4023 (R4 or later) AM7023 (R4 or later) Dino-Eye Edge AM4025X AM7025X |
Support Resolution | Supported resolution varies by different models |
Save Formats | Image: JPEG (on iOS) / PNG (on Android) Video: MP4 |
Microtouch | Yes |